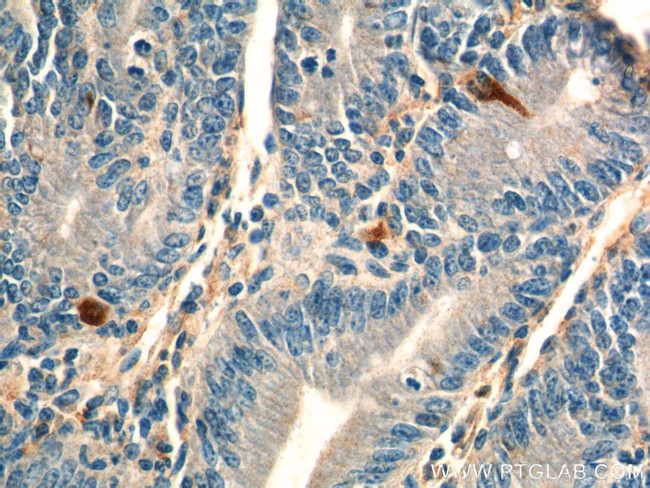
Chromogranin A Antibody in Immunohistochemistry (Paraffin) (IHC (P))

Search
Proteintech
Chromogranin A Polyclonal Antibody
{{$productOrderCtrl.translations['antibody.pdp.commerceCard.promotion.promotions']}}
{{$productOrderCtrl.translations['antibody.pdp.commerceCard.promotion.viewpromo']}}
{{$productOrderCtrl.translations['antibody.pdp.commerceCard.promotion.promocode']}}: {{promo.promoCode}} {{promo.promoTitle}} {{promo.promoDescription}}. {{$productOrderCtrl.translations['antibody.pdp.commerceCard.promotion.learnmore']}}
产品信息
23342-1-AP
种属反应
宿主/亚型
分类
类型
抗原
偶联物
形式
浓度
规格
纯化类型
保存液
内含物
保存条件
运输条件
产品详细信息
Immunogen sequence: LPVNSPMNK GDTEVMKCIV EVISDTLSKP SPMPVSQECF ETLRGDERIL SILRHQNLLK ELQDLALQGA KERAHQQKKH SGFEDELSEV LENQSSQAEL KEAVEEPSSK DVMEKREDSK EAEKSGEATD GARPQALPEP MQESKAEGNN QAPGEEEEEE EEATNTHPPA SLPSQKYPGP QAEGDSEGLS QGLVDREKGL SAEPGWQAKR EEEEEEEEEA EAGEEAVPEE EGPTVVLNPH PSLGYKEIRK GESRSEALAV DGAGKPGAEE AQDPEGKGEQ EHSQQKEEEE EMAVVPQGLF RGGKSGELEQ EEERLSKEWE DSKRWSKMDQ LAKELTAEKR LEGQEEEEDN RDSSMKLSFR ARAYGFRGPG PQLRRGWRPS SREDSLEAGL PLQVRGYPEE KKEEEGSANR RPEDQELESL SAIEAELEKV AHQLQALRRG (19-457 aa encoded by BC006459)
靶标信息
Chromogranin A (CHGA) is a member of the chromogranin/secretogranin family of neuroendocrine secretory proteins. It is found in secretory vesicles of neurons and endocine cells. CHGA is a precursor to three biologically active peptides: vasostatin, pancreastatin, and parastatin. These peptides act as autocine or paracrine negative modulators of the neuroendocrine system. CHGA is an excellent marker for carcinoid tumors, pheo-chromocytomas, paragangliomas, and other neuro-endocrine tumors. Coexpression of chromogranin A and neuron specific enolase (NSE) is common in neuroendocrine neoplasms.
仅用于科研。不用于诊断过程。未经明确授权不得转售。
生物信息学
蛋白别名: betagranin (N-terminal fragment of chromogranin A); catestatin; CgA; chromofungin; chromogranin A; chromogranin A precursor; Chromogranin-A; CTNNB; DKFZp686D02253; FLJ25606; FLJ37923; MGC105435; parathyroid secretory protein 1; Pituitary secretory protein I; SP-I; unnamed protein product
基因别名: CGA; CHGA; ChrA; PHE5; PHES
UniProt ID: (Human) P10645, (Mouse) P26339
Entrez Gene ID: (Human) 1113, (Mouse) 12652